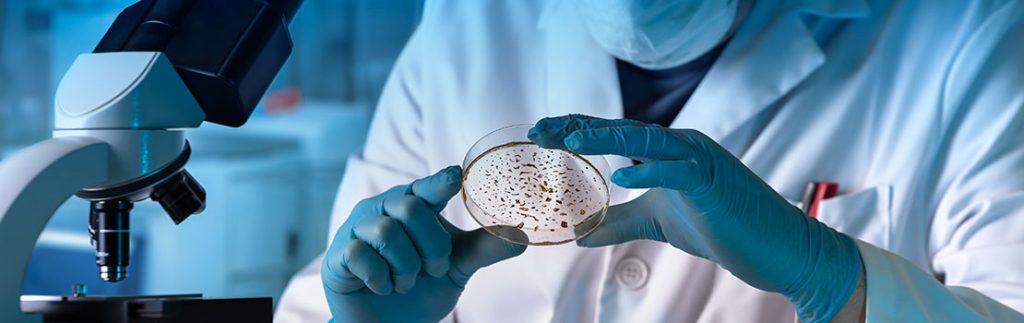

Análise microbiológica: descubra a importância
de escolher a membrana correta
Conheça algumas ações fundamentais para o dia a dia
De fato, a análise microbiológica tem grande importância para diversos setores da indústria, mas, você sabe como funciona esse procedimento e quais as características que devem ser levadas em conta durante a sua realização?
Primeiramente, é importante ressaltar que os processos de análise microbiológica, são essenciais para o estudo de microrganismos. Dessa forma, está presente no decorrer da cadeia de produção de alimentos, tratamento da água entre outras atividades de extrema importância para o bem-estar e saúde de todas as pessoas.
A sua importância se justifica devido ao que chamamos de Doenças Transmitidas por Alimentos (DTA) que, são muito comuns em diversas regiões do pais. No período de 2007 a 2021, por exemplo, foram contabilizados 25.509 casos, na cidade de São Paulo.
Dentre esses anos, 2011, 2012 e 2013 se destacaram por apresentarem a maior porcentagem, totalizando 33,7% dos casos.
Um número alarmante quando comparado com os 3 últimos anos que apresentaram baixa no número de contaminação por patógenos presentes em alimentos.
Em 2019, 2020 e 2021 foram contatados 2.059 casos, apenas 8,1% dos dados coletados no período.
Essa queda está relacionada com o desenvolvimento de tecnologias que auxiliam na análise microbiológica e evolução das diretrizes para a realização das atividades que envolvem o manuseio de alimentos.
Quer entender mais sobre o papel da análise microbiológica na sua área de atuação? Continue a leitura e tire todas as suas dúvidas!
Afinal, como é realizada a análise microbiológica?
Como dissemos anteriormente, o processo de análise microbiológica é essencial para indústria alimentícia, assim como, também o é, para o setor farmacêutico, de tratamento de água entre outros diversos setores.
Mas, você sabe como esse procedimento é aplicado no cotidiano dessas cadeias de produção e estudos?
Em primeiro lugar, é preciso entender que cada caso apresenta uma necessidade. Por isso, podemos encontrar diversos métodos.
Hoje, vamos explicar o papel da filtração e suas variáveis nesse recurso tão importante da indústria, como é aplicada e, quais as especificações para cada situação.
Acompanhe a leitura e fique por dentro de tudo sobre o assunto!
A filtração em análise microbiológica
A filtração, é o processo de implementação de uma barreira física para retenção de particulados em um fluxo, seja ele líquido ou gasoso.
Sendo assim, por meio da aplicação de um meio de contenção, é possível impedir a passagem de partículas e, assim, realizar o estudo dos componentes presentes na substância filtrada.
Entretanto, existem cuidados a serem tomados, principalmente, para aumentar precisão dos resultados obtidos. Por exemplo, é preciso entender qual membrana deve ser utilizada em cada situação.
Dessa forma, é possível definir as características de um composto por meio de processos de filtração qualitativos e quantitativos.
Entenda como definir a membrana certa
Desde a década de 1960, membranas são aplicadas no processo de tratamento da água e outros inúmeros setores. Assim, durante o seu desenvolvimento, foram descobertas diversas formas para realizar o procedimento. Entre eles, podemos citar:
- Microfiltração;
- Ultrafiltrarão;
- Nanofiltração.
A usabilidade dessas membranas, está associada à necessidade e especificidades dos processos a serem realizados. Assim como, a importância da precisão nos resultados obtidos.
Microfiltração
O processo de microfiltração, é a forma de separação por membrana que mais se assemelha ao processo de filtração comum. Isso porque, utiliza membranas com poros que vão 0,1 a 10μm.
Dessa forma, seu uso é indicado para substâncias que podem apresentar protozoários, bactérias, e alguns tipos de vírus e partículas.
Um dos principais pontos a serem pensados quando falamos em membrana para microfiltração, é a pressão utilizada para a passagem da substância. Nos casos que envolvem a microfiltração, a força aplicada deve ser mais baixa que as demais, devido a sua abertura maior, não podendo ultrapassar 3 bar.
Ultrafiltração
Na ultrafiltração, é possível bloquear a passagem tanto dos componentes que são retidos na microfiltração quanto coloides e todos os tipos de vírus.
Esse processo que, também, pode ser chamado de filtração molecular, realiza a separação dos componentes presentes na substância através de uma membrana classificada como semipermeável.
Ao contrário da anterior, as membranas para ultrafiltração apresentam poros com tamanhos calculados na faixa de 1 a 100 nm.
Nanofiltração
Por último, mas não menos importante, o processo de nanofiltração, muito utilizado pelo setor industrial, ideal para a separação de soluções heterogêneas e componentes dissolvidos em água.
Essa técnica ainda atua como uma barreira seletiva e pode permitir a passagem de alguns componentes, além de poder reter particulados com até 0,001 μm, sobre uma pressão que pode partir de 10 até 25 bar.
Soluções GVS
A GVS, conta com soluções para auxiliar você no processo de microfiltração para análise microbiológica, independente da sua área de atuação.
Atuamos, desde 1979, na fabricação de filtros para diversos segmentos, como: Life Science, MedTech e Safety.
Para oferecermos as melhores soluções no ramo de filtração para a sua empresa, contamos com um sistema rigoroso de análise de qualidade. Além de implementarmos, constantemente, formas para aprimoramento e desenvolvimentos dos sistemas de produção.
Dessa forma, oferecendo o que há de melhor, atualmente no mercado, em tecnologia de filtração. Da mesma forma, trabalhamos para fornecer uma experiência incomparável aos nossos clientes, com atendimento de qualidade para todos os segmentos atendidos.
As opções de equipamentos e filtros do nosso catálogo atendem no teste microbiológico dos seguintes segmentos:
- Água potável;
- Cervejas e vinhos;
- Águas residuais;
- Laticínios;
- Refrigerantes e concentrados;
- Sucos de frutas;
- Produtos fermentados;
Assim como, oferecemos opções que auxiliam na detecção de microrganismos, tais como:
- Bactérias, fungos e bolores;
- Escherichia coli;
- Estreptococos fecais e coliformes fecais;
- Estafilococos;
- Listeria monocytogenes;
- Estafilococos;
- Pseudomonas aeruginosa;
- Legionella.
Quer saber mais sobre os filtros que a GVS oferece para otimizar os estudos realizados pela sua empresa? Acesse nosso site e descubra a infinidade de soluções em nosso catálogo.
Além disso, oferecemos um guia completo sobre a linha direcionada à microbiologia da GVS, que explora todos os aspectos desse campo de atuação tão rico. Saiba mais sobre as soluções da GVS para a sua empresa, clicando aqui.
Fique por dentro de todas as novidades do mercado. Acompanhe nosso blog e tenha acesso a dicas, novas soluções e muito mais conteúdo!
Referências
https://www.prefeitura.sp.gov.br/cidade/secretarias/saude/vigilancia_em_saude/index.php?p=244330
https://www.in.gov.br/web/dou/-/resolucao-rdc-n-331-de-23-de-dezembro-de-2019-235332272
